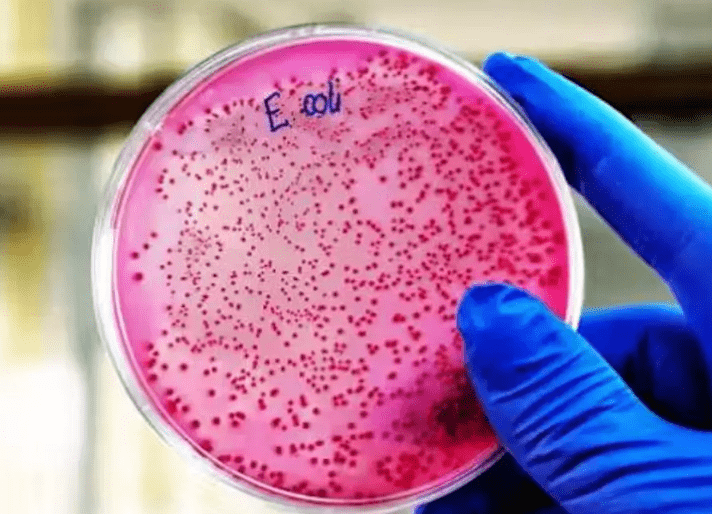

Un posible biomarcador temprano: la colibactina y el cáncer colorrectal en jóvenes
Un estudio internacional liderado por la Universidad de California en San Diego y el CNIO asocia la exposición infantil a la toxina colibactina, producida por cepas de Escherichia coli, con un mayor riesgo de cáncer colorrectal antes de los 40 años. Fundación Longenia...
El niño que puso rostro a la fibrosis quística, 30 años después: “La nueva medicación me ha cambiado la vida”
Hace tres décadas, un niño llamó la atención del mundo al convertirse en el símbolo de la lucha contra la fibrosis quística. Hoy, ya adulto, comparte su historia de esperanza tras experimentar los efectos de una nueva generación de medicamentos que han transformado su...
Científicos coreanos desarrollan una tecnología capaz de revertir el cáncer
Un equipo de científicos coreanos ha identificado un “interruptor molecular” capaz de revertir células cancerosas a su estado normal. Este hallazgo, publicado en la revista Advanced Science, se basa en la tecnología REVERT, que analiza datos de...
¿Y si un análisis de sangre pudiera predecir el riesgo de sufrir enfermedades al envejecer?
Un reciente artículo titulado “Proteomic organ-specific ageing signatures and 20-year risk of age-related diseases: the Whitehall II observational cohort study” explora cómo las firmas proteómicas permiten calcular “brechas de edad” en órganos para anticipar...